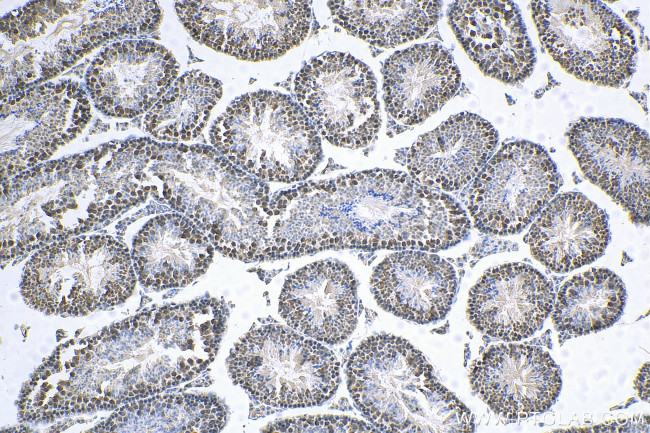
MED28 Antibody in Immunohistochemistry (Paraffin) (IHC (P))

Search
Proteintech
MED28 Polyclonal Antibody
{{$productOrderCtrl.translations['antibody.pdp.commerceCard.promotion.promotions']}}
{{$productOrderCtrl.translations['antibody.pdp.commerceCard.promotion.viewpromo']}}
{{$productOrderCtrl.translations['antibody.pdp.commerceCard.promotion.promocode']}}: {{promo.promoCode}} {{promo.promoTitle}} {{promo.promoDescription}}. {{$productOrderCtrl.translations['antibody.pdp.commerceCard.promotion.learnmore']}}
产品信息
16262-1-AP
种属反应
宿主/亚型
分类
类型
抗原
偶联物
形式
浓度
规格
纯化类型
保存液
内含物
保存条件
运输条件
产品详细信息
Immunogen sequence: MAAPLGGMF SGQPPGPPQA PPGLPGQASL LQAAPGAPRP SSSTLVDELE SSFEACFASL VSQDYVNGTD QEEIRTGVDQ CIQKFLDIAR QTECFFLQKR LQLSVQKPEQ VIKEDVSELR NELQRKDALV QKHLTKLRHW QQVLEDINVQ HKKPADIPQG SLAYLEQASA NIPAPLKPT (1-178 aa encoded by BC011936 )
靶标信息
The mediator complex is a multi-protein transcriptional co-activator that is expressed ubiquitously in eukaryotes from yeast to mammals and is required for induction of RNA polymerase II (pol II) transcription by DNA binding transcription factor. One of the proteins in this complex is MED28, also known as Magicin. MED28 is expressed in many cell lines and tissues. It has been shown that a down-regulation of MED28 expression in NIH3T3 cells results in a significant induction of several genes associated with smooth muscle cell differentiation and conversely its over-expression represses expression of SMC genes. MED28 can also form a ternary complex with Grb2 and Merlin, the neurofibromatosis 2 tumor suppressor protein, indicating that MED28 may play a role in Merlin's tumor suppressive activity. MED28 has also been recently identified as an HIV dependency factor (HDF), suggesting that MED28 may be an important drug target in HIV treatment. At least two isoforms of MED28 are known to exist.
仅用于科研。不用于诊断过程。未经明确授权不得转售。
篇参考文献 (0)
生物信息学
蛋白别名: endothelial-derived; endothelial-derived gene 1; Endothelial-derived protein 1; Magicin; Mediator complex subunit 28; Mediator of RNA polymerase II transcription subunit 28; mediator of RNA polymerase II transcription, subunit 28 homolog; Merlin and Grb2-interacting cytoskeletal protein; Tumor angiogenesis marker EG-1
基因别名: 1500003D12Rik; AI451633; AU045690; EG1; FKSG20; magicin; MED28; RGD1305875
UniProt ID: (Human) Q9H204, (Rat) P68943, (Mouse) Q920D3
Entrez Gene ID: (Human) 80306, (Rat) 305391, (Mouse) 66999